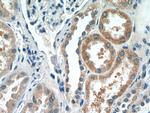
DPEP2 Antibody in Immunohistochemistry (Paraffin) (IHC (P))

Search
Proteintech
DPEP2 Polyclonal Antibody
{{$productOrderCtrl.translations['antibody.pdp.commerceCard.promotion.promotions']}}
{{$productOrderCtrl.translations['antibody.pdp.commerceCard.promotion.viewpromo']}}
{{$productOrderCtrl.translations['antibody.pdp.commerceCard.promotion.promocode']}}: {{promo.promoCode}} {{promo.promoTitle}} {{promo.promoDescription}}. {{$productOrderCtrl.translations['antibody.pdp.commerceCard.promotion.learnmore']}}
产品信息
16466-1-AP
种属反应
已发表种属
宿主/亚型
分类
类型
抗原
偶联物
形式
浓度
规格
纯化类型
保存液
内含物
保存条件
运输条件
产品详细信息
Immunogen sequence: CAYTTPGPP RAQFWSAYVP CQTQDRDALR LTLEQIDLIR RMCASYSELE LVTSAKALND TQKLACLIGV EGGHSLDNSL SILRTFYMLG VRYLTLTHTC NTPWAESSAK GVHSFYNNIS GLTDFGEKVV AEMNRLGMMV DLSHVSDAVA RRALEVSQAP VIFSHSAARG VCNSARNVPD DILQLLKKNG GVVMVSLSMG VIQCNPSANV STVADHFDHI KAVIGSKFIG IGGDYDGAGK FPQGLEDVST YPVLIEELLS RGWSEEELQG VLRGNLLRVF RQVEKVQEEN KWQSPLEDKF PDEQLSSSCH SDLSRLRQRQ SLTSGQELTE IPIHWTAKLP AKWSVSESS (32-379 aa encoded by BC024021)
靶标信息
Probable metalloprotease which hydrolyzes leukotriene D4 (LTD4) into leukotriene E4 (LTE4).
仅用于科研。不用于诊断过程。未经明确授权不得转售。
生物信息学
蛋白别名: Dipeptidase 2; MBD-2; Membrane-bound dipeptidase 2; putative membrane-bound dipeptidase 2; unnamed protein product
基因别名: DPEP2; F630103D06Rik; MBD-2; MBD2; UNQ284/PRO323
UniProt ID: (Human) Q9H4A9, (Rat) Q5M872, (Mouse) Q8C255
Entrez Gene ID: (Human) 64174, (Rat) 291984, (Mouse) 319446